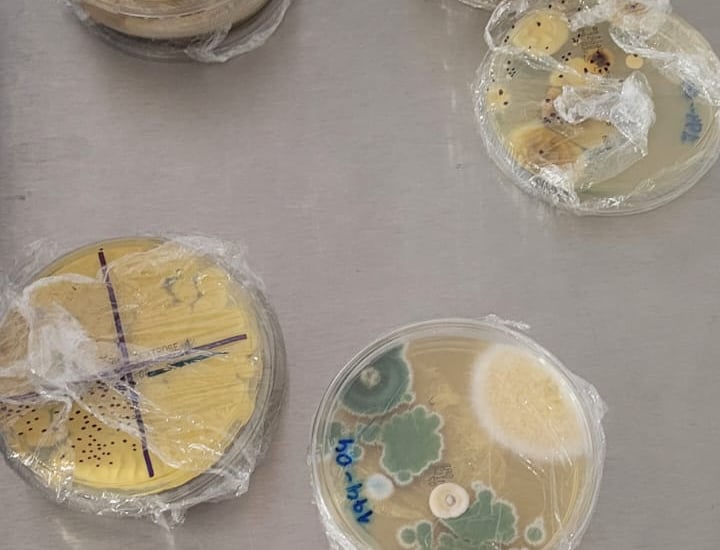
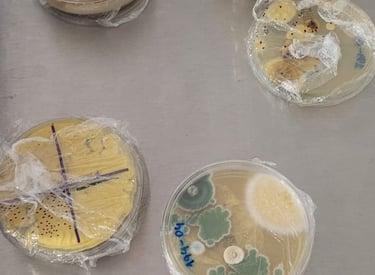
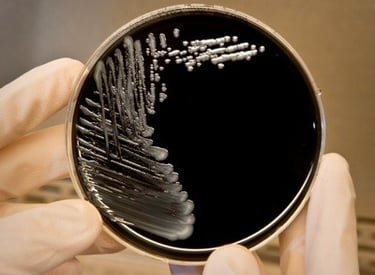
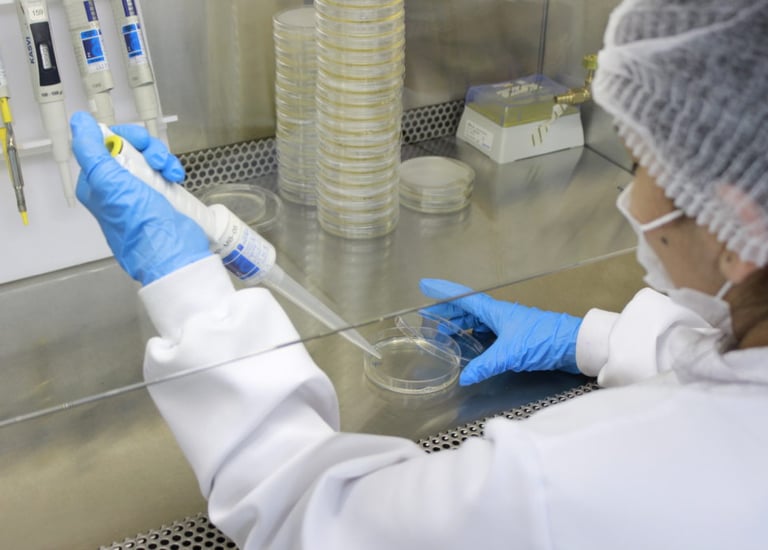
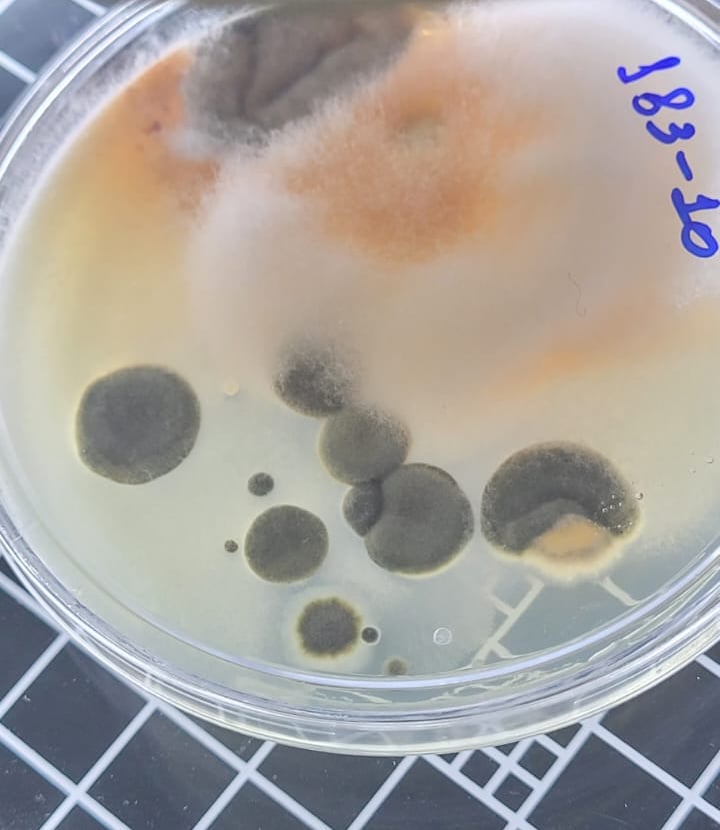
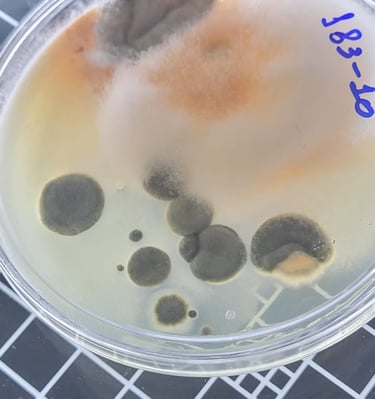

Excelência em Análises Químicas e Biológicas
No Laboratório AMB, garantimos qualidade e eficiência em análises da qualidade do ar interior, análises de legionella, análise de laboratório e potabilidade da água, sempre seguindo as normas vigentes para resultados confiáveis.
+1537
Resultados Confiáveis Sempre
Qualidade Superior
Análises químicas e biológicas com excelência e precisão garantidas.

Monitoramento da qualidade da água em ambientes controlados.

Avaliação da qualidade do ar interior em ambientes climatizados.

Testes rigorosos para garantir a potabilidade da água.
Compromisso com a eficácia e eficiência em análises.
Qualidade Garantida
Excelência em análises químicas e biológicas no Rio de Janeiro.

Links Rápidos
Conecte-se conosco
Contato
